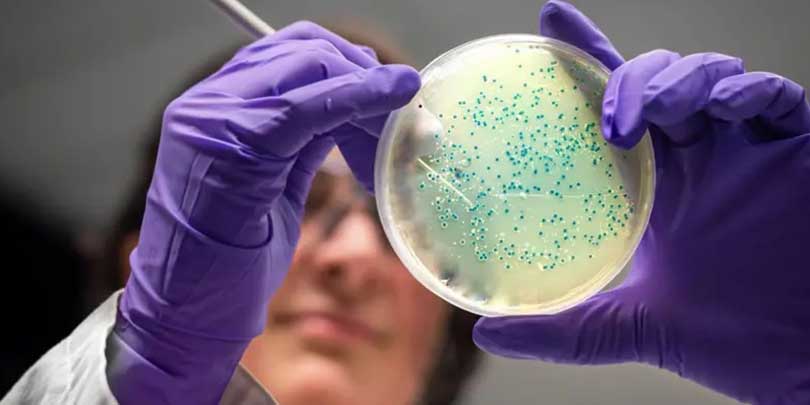

एआईले दुई नयाँ एन्टिबायोटिकको विकास
लण्डन । आर्टिफिसियल इन्टेलिजेन्स (एआई)ले दुई नयाँ एन्टिबायोटिक विकास गरेको छ ।
यसले एन्टिबायोटिक प्रतिरोधी क्षमता विकास गरेका गोनोरिया र एमआरएसए सुपरबगहरूलाई मार्न सक्नेछ ।
प्रयोगशाला र जनावरमा गरिएका परीक्षणमा यी सुपरबगलाई मार्न सफल भएका छन् । दुवै यौगिक धेरै वर्षसम्म परिष्कृत गरिने र निरन्तर परीक्षण गरिनेछन् । त्यसपछि मात्र यीनीहरूलाई प्रिस्क्रिप्शनको रूपमा अर्थात् आम मानिसले प्रयोग गर्न सक्ने जनाइएको छ ।
यसको पछाडि रहेको म्यासाचुसेट्स इन्स्टिच्युट अफ टेक्नोलोजी (एमआईटी)को टोलीले एआईले एन्टिबायोटिक खोजमा दोस्रो स्वर्ण युग सुरु गर्न सक्ने बताएको छ ।
प्रतिरोधात्मक क्षमता विकास भएका संक्रमणको उपचार
एन्टिबायोटिकले ब्याक्टेरियालाई मार्छ। तर अहिले एन्टिबायोटिक प्रतिरोधात्मक क्षमता विकास गरेका संक्रमण (ब्याक्टेरिया)का कारण प्रत्येक वर्ष दस लाखभन्दा बढी मानिस मरिरहेका छन् ।
एन्टिबायोटिकको अत्यधिक प्रयोगले ब्याक्टेरियालाई औषधिको प्रभावबाट बच्न आफूलाई परिवर्तन गर्न मद्दत गरेको विज्ञहरू विश्वास गर्छन् ।
विगत केही दशकदेखि नयाँ एन्टिबायोटिकको अभाव छ । यसअघि अनुसन्धानकर्ताहरूले नयाँ एन्टिबायोटिक बन्न सक्ने सम्भावना भएका रासायनिक यौगिकहरू फेला पार्न हजारौं उपलब्ध रसायनहरूको खोजी गर्न एआई प्रयोग गरेका छन् ।
अब एमआईटी टोलीले यस दिशामा एक कदम अगाडि बढाएको छ । एन्टिबायोटिक डिजाइन गर्न जेनेरेटिभ एआई प्रयोग गरेको छ ।
यी एन्टिबायोटिकहरू सुरुमा यौन संचारित रोग गोनोरिया र सम्भावित रूपमा जीवनलाई खतरामा पार्ने मेथिसिलिन–प्रतिरोधी स्टेफिलोकोकस ऑरियस वा एमआरएसएका लागि विकसित गरिएको थियो ।
अनुसन्धानकर्ताहरूको अध्ययन सेल नामक जर्नलमा प्रकाशित भएको छ । अनुसन्धानमा ३.६ करोड यौगिकहरूको जाँच गरिएको थियो । यसमा धेरै त्यस्ता यौगिकहरू समावेश थिए जुन या त अहिलेसम्म अवस्थित छैनन् वा पत्ता लागेका छैनन् ।
बिचार/ब्लग

कांग्रेसलाई किन विभाजन गर्न खोजिँदैछ ?
कुन्दनराज काफ्ले, नेता, नेपाली कांग्रेस
कांग्रेसबारे म फेरि केही कुरा लेख्न बाध्य भएँ
यामबहादुर मल्ल (रामकृष्ण), नेता, नेपाली कांग्रेस
कांग्रेस पार्टी रूपान्तरणका नाममा अहङ्कार कि विनाश ?
यामबहादुर मल्ल (रामकृष्ण)







फेसबुकबाट तपाईको प्रतिक्रिया